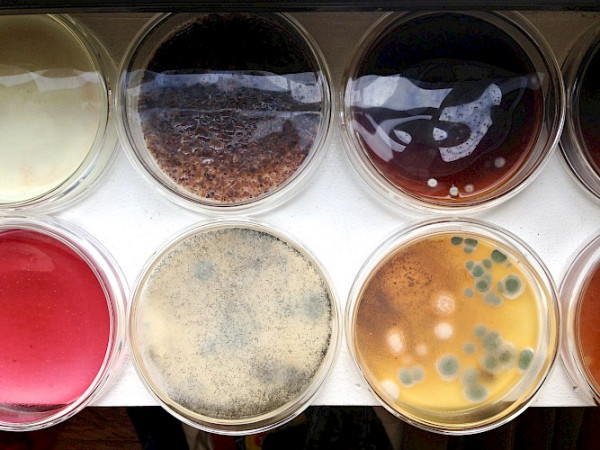

Prof. Hodges has published an essay, Fungal Memories: Flourishing in Decay to Asia Art Archive’s LIKE A FEVER online journal. It is part of the series What Time Tells, “an ongoing series on time and the problems we face today.” His contribution considers what we might learn from fungus and mould in dealing with what Berlant has called the “crisis ordinariness.” Having lived in the especially humid climate of Macao for so many years, Hodges reflects on daily practices of care to keep mould and fungus at bay. The essay also reflects on what we might also learn from their ability to flourish in such conditions.